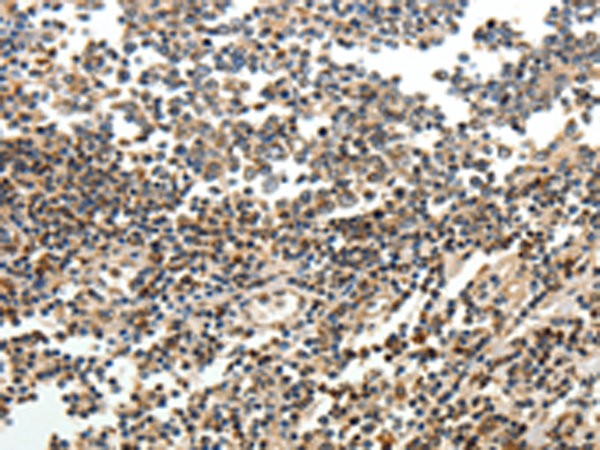

中文名稱:兔抗SERPINF1多克隆抗體
英文名稱: Anti-SERPINF1 rabbit polyclonal antibody
別 名: OI6, OI12, PEDF, EPC-1, PIG35
抗 原: SERPINF1
儲 存: 冷凍(-20℃)
宿 主: Rabbit
相關類別: 一抗
反應種屬: Human, Mouse
標記物: Unconjugate
克隆類型: rabbit polyclonal
技術規格
|
Background: |
The protein encoded by this gene is a member of the serpin family, although it does not display the serine protease inhibitory activity shown by many of the other serpin family members. The encoded protein is secreted and strongly inhibits angiogenesis. In addition, this protein is a neurotrophic factor involved in neuronal differentiation in retinoblastoma cells. |
|
Applications: |
ELISA, WB, IHC |
|
Name of antibody: |
SERPINF1 |
|
Immunogen: |
Fusion protein of human SERPINF1 |
|
Full name: |
serpin peptidase inhibitor, clade F (alpha-2 antiplasmin, pigment epithelium derived factor), member 1 |
|
Synonyms: |
OI6, OI12, PEDF, EPC-1, PIG35 |
|
SwissProt: |
P36955 |
|
ELISA Recommended dilution: |
1000-5000 |
|
IHC positive control: |
Human tonsil |
|
IHC Recommend dilution: |
15-50 |
|
WB Predicted band size: |
46 kDa |
|
WB Positive control: |
K562 cells |
|
WB Recommended dilution: |
200-1000 |

購物車
購物車 幫助
幫助
 021-54845833/15800441009
021-54845833/15800441009
